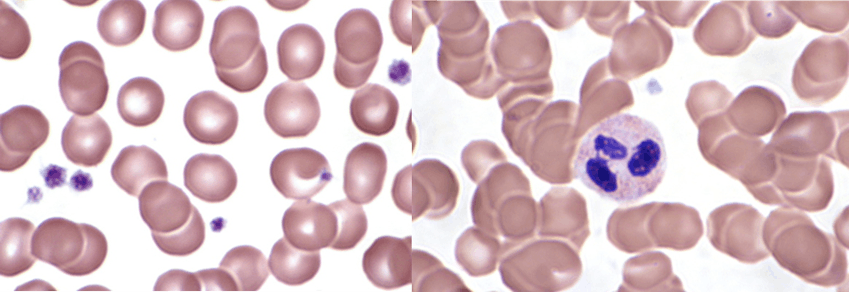

Skip to content
As an independent contractor, I do not have allegiance to a particular point of view.I have reviewed a variety of cases regarding questions of standard of care, disease risk, causation, and liability. I analyze complex medical issues and boil them down to their essence, providing a concise analysis for medical, personal, or legal purposes.







 Mid-Atlantic Medical Consulting
Mid-Atlantic Medical Consulting
Comprehensive Concise Analysis
MAMC Payments
Payments are now accepted by credit card, debit card, or ACH transfer! Click the link below. There is no additional charge:
Payments are due 30 days after billing.
For ongoing cases, a bill may be sent each month.
If you plan to mail a check, I will email you my home address
SPECIALIST IN HEMATOLOGY AND ONCOLOGY
R. Brian Mitchell, MD
14241 Midlothian Turnpike, #512
Midlothian, VA 23113
804-667-8903
mamc@5mitch.net




Comprehensive and careful review of the medical records


Prompt and reliable service


Clear and unbiased opinions based on the facts of the case


My Values
Impartiality: complete evaluation of a case before offering a professional opinion
Opinions based solely on the facts of the case
Opinions may support plaintiff or defense or neither side
Detailed and precise reports
Prompt and reliable service
Respect for the knowledge and skill of others
Cost sensitivity
Integrity, honesty, credibility, humility
Use of plain language and concise explanations
Clear explanations without over-simplification
Expert witness
Medical legal cases
Class action cases
Workman’s compensation
Personal injury
Family controversies
Expert case review
Plaintiff or defense
Standard of care
Causation
Aid in planning deposition questions
Expert clinical care
Independent consulting
Second opinions
Case summaries
My Values
Impartiality: complete evaluation of a case before offering a professional opinion
Opinions based solely on the facts of the case
Opinions may support plaintiff or defense or neither side
Detailed and precise reports
Prompt and reliable service
Respect for the knowledge and skill of others
Cost sensitivity
Integrity, honesty, credibility, humility
Use of plain language and concise explanations
Clear explanations without over-simplification
MAMC Blog
30+ years of practicing clinical hematology, oncology, and internal medicine
23 years of clinical practice with Virginia Cancer Institute (VCI) in Richmond, VA
(Management team for 10 years and managing partner, 2014-17)
Assistant Professor of Medicine for 7 years at Virginia Commonwealth University, 1992-1999
Experience with basic science research, clinical research, clinical practice, academic medicine, and teaching
Strong focus on bedside manner, quality of life, supportive care, and patient independence
One of eight finalists and the only oncologist nominated for “Best Physician in Richmond” August 2017
Board certified in internal medicine, hematology, and oncology
Keywords
Lung cancer, colon cancer, pancreatic cancer, breast cancer, stomach cancer, lymphoma, multiple myeloma, clotting disorders, anemia, coagulation, clotting, bleeding disorders, hematology disorders, leukemia, lymphoma, Hodgkin’s disease, life-expectancy, expert witness, causation, delayed diagnosis
© 2020 by Mid-Atlantic Medical Consulting


Want to print your doc?
This is not the way.
This is not the way.

Try clicking the ··· in the right corner or using a keyboard shortcut (
CtrlP
) instead.